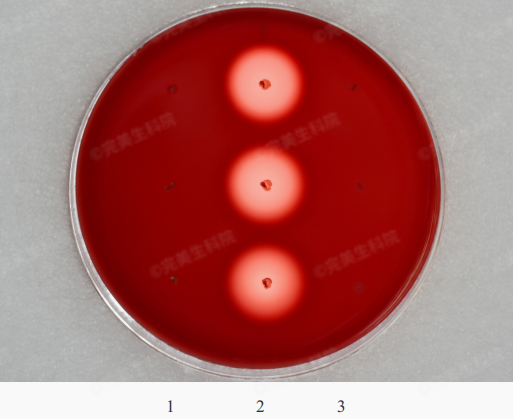

益生菌作为我们熟悉的微生物,对健康的促进作用已得到广泛的研究验证,如调节肠道微生态、调节免疫等。完美公司深耕肠道健康领域27年,致力于推动微生态研发成果产业化应用,助力改善人体健康。
上期文章 (点击查看),我们介绍了完美微生态研究平台的建设,以及一株拥有自主知识产权的益生菌:植物乳植杆菌LPPerfectus®001。今天,让我们进一步了解另一株完美自主知识产权益生菌——
鼠李糖乳酪杆菌LRPerfectus®158


益生菌若要从层层筛选中脱颖而出,离不开消化系统的“生存挑战”,具备人体胃肠液耐受性、能有效在肠道定植的益生菌,才有可能发挥健康作用。

耐胃酸、耐肠液能力实验
实验结果显示,鼠李糖乳酪杆菌LRPerfectus®158在人工胃肠液的存活率可达80%以上,高于同批次筛选的其他菌株。
为观察鼠李糖乳酪杆菌LRPerfectus®158的肠道定植存活能力,研究人员将其进行细胞染色剂CM-Dil标记后,让斑马鱼进食摄入。随着斑马鱼进食停止,不能黏附定植于肠道的益生菌会被逐渐排出肠腔。

肠道定植存活能力实验
利用斑马鱼胚胎透明的特性,通过观察停止进食后活菌在斑马鱼肠腔内的荧光强度变化,我们可以直观地判断活菌在肠道的黏附定植能力。
斑马鱼肠腔定植存活实验显示,停止进食18h、48h后,肠腔内鼠李糖乳酪杆菌LRPerfectus®158平均荧光强度约为停止进食时的60%、23%,且被排出肠腔速率与对照菌株无显著差异,说明该菌株可以通过口服到达斑马鱼肠道部位,且黏附能力较强。
人工胃液、人工肠液、斑马鱼肠腔定植实验显示,鼠李糖乳酪杆菌LRPerfectus®158具有较高的耐胃酸、耐肠液、肠腔定植存活能力,具有优异的肠道表现力,为其与宿主相互作用发挥益生功能提供了前提条件。

经体外实验、模式生物(线虫、斑马鱼)及动物实验 (小鼠、大鼠)等一系列功效研究,鼠李糖乳酪杆菌LRPerfectus®158在改善非细菌性腹泻、抑制病原菌改善炎症、增强运动耐力、改善急性结肠炎等方面表现出较好的健康效应。
1.改善非细菌性腹泻
生活中,人们可能会因饮食不当引发非细菌性腹泻。有研究表明,斑马鱼肠腔在功能上与人哺乳动物存在同源性,可采用番泻叶对斑马鱼进行造模实验,研究鼠李糖乳酪杆菌LRPerfectus®158在改善非细菌性腹泻方面的健康效应。


实验发现,腹泻斑马鱼食用鼠李糖乳酪杆菌LRPerfectus®158 6小时后,肠腔尼罗红荧光增加,说明排泄速度变慢、肠道蠕动率逐渐接近正常。
这表明鼠李糖乳酪杆菌LRPerfectus®158可显著改善斑马鱼非细菌性腹泻,改善率达35.44%。
2.抑制病原菌改善炎症

斑马鱼体内试验显示,鼠李糖乳酪杆菌LRPerfectus®158能较好地抑制阴道加德纳氏菌、白色假丝酵母、单增李斯特菌、艰难梭菌、黏附侵袭性大肠杆菌(AIEC)等病原菌,并改善对应炎症。
通过上述试验可推测,鼠李糖乳酪杆菌LRPerfectus®158在抑制细菌和真菌混合性感染的阴道炎,以及各类肠道炎症上均有一定的功效。
3.增强运动耐力

增强运动耐力
负重游泳时间可直接反映机体的运动耐力情况。在给实验小鼠喂食鼠李糖乳酪杆菌LRPerfectus®158 30天后,发现其负重游泳力竭时间显著延长,说明该菌株可增强小鼠运动耐力。
增加机体运动后能量物质储备
肝糖原是机体运动时的重要供能物质,实验发现,摄入鼠李糖乳酪杆菌LRPerfectus®158可增加小鼠游泳运动后体内肝糖原的含量,有助于提供持久的能量以支撑持续性运动。
清除机体运动代谢产物
当运动量达到一定程度后,机体血尿素氮含量、乳酸大量堆积,会影响运动能力,常见的便是出现肌肉酸痛等情况。与空白组比,食用鼠李糖乳酪杆菌LRPerfectus®158显著降低了游泳小鼠体内尿素和乳酸含量,可清除机体运动代谢产物。
综上研究表明,鼠李糖乳酪杆菌LRPerfectus®158可以显著增强小鼠运动耐力、增加机体能量物质储备、清除运动代谢产物,有助于运动后恢复。
4.缓解急性结肠炎
研究人员给实验小鼠食用28天鼠李糖乳酪杆菌LRPerfectus®158后,用DSS构建急性结肠炎模型。

结果发现,鼠李糖乳酪杆菌LRPerfectus®158可延缓结肠变短、改善溃疡症状、降低炎症因子,缓解急性结肠炎症状。

鼠李糖乳酪杆菌LRPerfectus®158通过了严格的安全性评估,包括菌株毒力和耐药基因分析,以及药物敏感性、溶血性、动物致病性等验证。
1.毒力和耐药基因分析

与国内外主流的毒力基因数据库 (VFDB)、耐药基因数据库 (包括CARD、ecoh、megares、plasmidfinder、ResFinder、Argannot、NCBI) 中存储的序列进行比对,结果显示其无毒力基因、无可转移耐药基因。
2.抗生素敏感性分析

结果:对该菌种常见抗生素无耐药性
3.溶血性检测

结果:该菌株无溶血性
4.细菌致病性试验
研究人员参考《保健食品原料用菌种安全性检验与评价技术指导原则(2020年版)》中的“保健食品原料用细菌致病性检验方法”对其开展小鼠细菌致病性研究。

小鼠细菌致病性(腹腔注射)实验结果

小鼠细菌致病性(经口灌胃)实验结果
结果显示,小鼠腹腔注射和经口灌胃期间,小鼠状态正常,无中毒体征和死亡情况,即鼠李糖乳酪杆菌LRPerfectus®158无致病性。
经毒力和耐药基因分析以及药物敏感性、溶血性、动物致病性试验验证,可以确认鼠李糖乳酪杆菌LRPerfectus®158是一株安全菌株。
综上所述,一系列科学研究表明,这株完美自主知识产权的鼠李糖乳酪杆菌LRPerfectus®158不仅具备耐胃酸、耐肠液等优良性能,容易定植于肠道发挥作用,更是拥有改善非细菌性腹泻、抑制病原菌改善炎症、增强运动耐力等多种健康效应,有着巨大的应用潜力。
来源:完美生科院
责编:周听听
一审:周听听
二审:喻志科
三审:熊佳斌
来源:新湖南客户端

湖南日报新媒体

